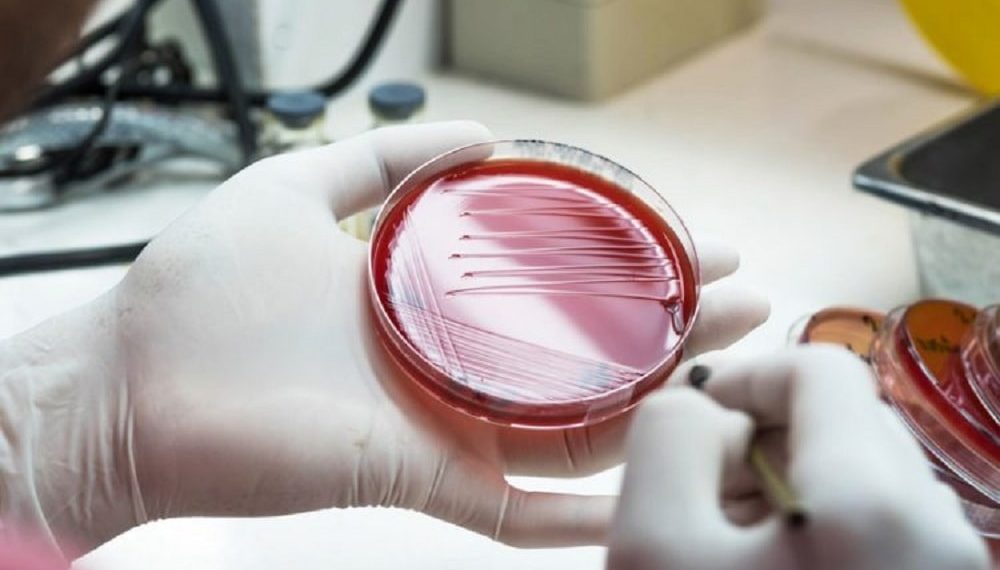

Turns out, discarded antibiotic compounds could be developed for new life-saving drugs.In the heyday of antibiotic development in the mid-20th century, many different chemical compounds with antibacterial properties were examined, but only a small proportion was selected for development into drugs.
As the fight against drug-resistant infections continues, biological scientists and chemists at the University of Leeds re-examined these old compounds, applying advances in science and technology to test more precisely whether they could still hold the key to a future drug.
Dr Alex O’Neill, from the Antimicrobial Research Centre at the University, said, “We’re showing the value of reviewing compounds previously put on the back of the shelf. Amongst the 3,000 or so antibiotics discovered to date, only a handful has been brought into clinical use. There may be a wealth of compounds out there with untapped potential”.
Dr O’Neill’s latest research found that a compound identified in the 1940s could now be a realistic contender as the basis of a new antibiotic drug.
A family of compounds, known as the actinorhodin, was originally identified as having weak antibiotic properties, but was not taken forward for development into a drug.
However, Dr O’Neill said that at the time scientists did not fully differentiate the individual compounds within the family when they examined them, leading to a less than precise picture of their properties.
Dr O’Neill and colleague Professor Chris Rayner from the University’s School of Chemistry believed the compound is worth serious consideration as the basis for a new drug to combat certain types of bacterial infections.
Dr O’Neill added, “A major challenge in tackling the problem of antibiotic resistance is to discover new drugs – our study shows that potentially useful drug candidates can be ‘discovered’ from amongst the antibiotics we already know about”.
Also based in the School of Chemistry is Dr Michael Webb, whose research focuses on a compound, called pentyl pantothenamide, first assessed in the 1970s.
Then, it was found to be able to stop the growth of E.coli but not completely kill the bacteria, so was never taken into clinical use.
Dr Webb said, “The results of our latest study open up the possibility of designing new drugs that use the same means to attack E. coli, but in a more effective way”.
Dr O’Neill concluded, “Our findings underscore the importance of revisiting unexploited antibiotics as a potential source of new antibiotic drug candidates. We now believe a comprehensive re-evaluation of such compounds is
worthwhile, potentially offering new ways to protect against infections”.
The study is published in the journal Scientific Reports.